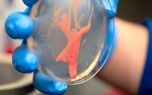
راز یک قاتل نامرئی کشف شد/ این باکتری مرموز گیاهان را از پا درمی‌آورد

خلاصه خبر با نوبان - هوش مصنوعی درستون
یک لایه محافظتی عجیبوغریبرالستونیا مانند بسیاری از باکتریها، با ترشح یک پوشش محافظ به نام بیوفیلم از خود محافظت میکند.
این ماده بهطور غیرمعمولی شُل و روان است و به باکتری کیفیت لزج و لجنی میدهد.
ورود فیزیک به میدانهَری مَنیکانتان (Hari Manikantan)، استاد مهندسی شیمی که به مطالعه سیالات پیچیده علاقه دارد، وارد این پژوهش شد.
ممکن است در برابر یک ضربه ناگهانی مثل جامد سفت واکنش نشان دهند، اما در طول زمان مثل یک مایع غلیظ جریان یابند.
آنها کشف کردند که این ماده لجنی بهراحتی زیر فشار و جریانی که در رگهای گیاه وجود دارد، جریان مییابد.
- نوبان
در تازهترین خبرها، اکو ایران: رضا رشیدپور مجری پیشین صداوسیما بعد از اقدام جنجالی و توهینآمیز شبکه افق، با انتشار یک استوری اینستاگرامی، کمپین برکناری رئیس سازمان صداوسیما را راه انداخت و نوشت: عزل پیمان جبلی یک مطالبه حداقلی است. در ادامه، رهبر جریان حکمت ملی عراق از اظهارات اخیر دونالد ترامپ رئیسجمهوری عراق علیه نوری مالکی نامزد چارچوب هماهنگی شیعیان برای تصدی پست نخستوزیری انتقاد کرد. همچنین، تهران-ایرنا-یک کارشناس مسائل رژیم صهیونیستی هشدار داد تشدید تنشهای اخیر نشاندهنده تلاش اسرائیل برای تحمیل قواعد درگیری جدیدی است که برتری آن را در مرحله آینده تضمین کند. از سوی دیگر، تهران-ایرنا-یک مقام حقوق بشری یکشنبه شب اعلام کرد که تصمیم رژیم صهیونیستی برای پایان دادن به فعالیتهای سازمان «پزشکان بدون مرز» و ابلاغ دستور توقف فعالیت و خروج این سازمان از غزه، در چارچوب سیاست فشار و باجخواهی نظاممند اسرائیل علیه نهادهای انسانی فعال در این منطقه اتخاذ شده است. در همین حال، متن شبنامه انصاف یکشنبه ۱۲ بهمن ۱۴۰۴ را در زیر میخوانید. همزمان، اکو ایران: مقامهای رسمی غربی به رسانه آمریکایی گفتهاند کشورهای حاشیه خلیجفارس همزمان با فشارهای دولت «دونالد ترامپ» رئیسجمهور آمریکا علیه ایران به مقامات آمریکایی هشدار میدهند که برنامه موشکی ایران قادر است آسیب قابل توجهی به منافع آمریکا در منطقه وارد کند. در ادامه، متن اطلاعیهی دفتر رئیسجمهور پزشکیان دربارهی حوادث اخیر ناآرامیها و اعتراضات دی ۱۴۰۴ به همراه جدول متنی اسامی جانباختگان به شرح زیر است: بسمالله الرحمن الرحیم ایران عزیزمان این روزها در کنار و همدرد خانوادههایی است که در سوگ سنگین جان باختن عزیزان خود به سر میبرند.
- نوبان